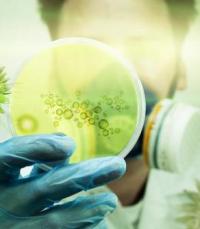

Hal ini diduga lantaran pria tersebut sempat berinteraksi dengan pria asal Indiana yang positif terjangkit MERS.
"Keduanya memiliki pertemuan bisnis sesaat sebelum pasien Indiana positif mengidap MERS. Kami berpikir pria ini mungkin terinfeksi MERS, tapi secara teknis dia tidak memiliki tanda-tanda dari gejala yang ditimbulkan akibat MERS," kata manager untuk aksi tanggap MERS, David Swerdlow, seperti dilansir
USA Today (Minggu, 17/5).
Swerdlow menjelaskan mengenai adanya indikasi pria itu mengidap MERS lantaran ia bertemu face to face dengan pria Indiana selama sekitar 40 menit. Bahkan Swerdlow mengatakan kalau kedua pria itu juga berjabat tangan.
"Saat ini ia sedang 'mengisolasi diri', di mana ia menghindari kontak dengan orang lain atau memakai masker wajah," lanjut Swerdlow.
[rus]
Jadikan RMOL.ID sumber pilihan pencarian Google
Temukan berita-berita hangat terpercaya dari RMOL.ID di Google News.
Untuk mengikuti silakan klik tanda bintang.
. Petugas kesehatan Amerika Serikat (Sabtu, 16/5) kembali menemukan seorang pria yang diduga terjangkit Middle East Respiratory Syndrome (MERS) atau flu Arab.
. Petugas kesehatan Amerika Serikat (Sabtu, 16/5) kembali menemukan seorang pria yang diduga terjangkit Middle East Respiratory Syndrome (MERS) atau flu Arab.
BERITA TERKAIT: